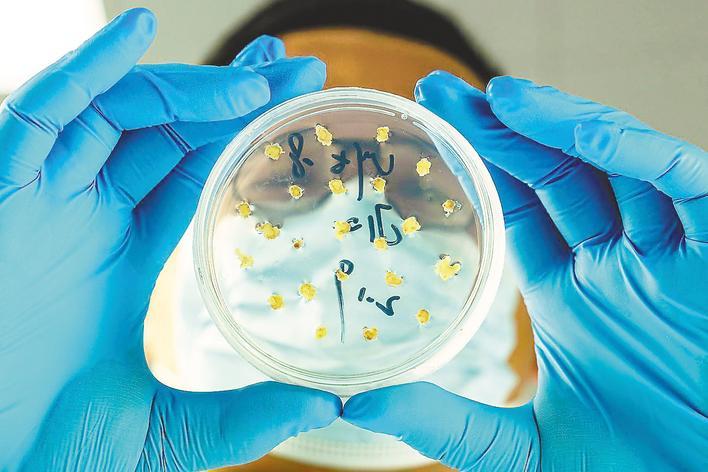

陈嘉丽 《健身步道》(组照)

肖佳法 《中国筑坝人——世界最大清洁能源走廊建设者肖像》

陈锡萍 《智能制造》(组照)
陈国兴 《镜鉴粮芯》(组照)

李葳 《武汉女足勇夺亚冠联赛冠军》

应文 《顶好》(组照)

雷佳民 《长江源头之雪豹》(组照)

李莉莉 《大山里的精灵》(组照)
湖北日报全媒记者 文俊 通讯员 王旭 王艺杰
长江从青藏高原奔涌而下,蜿蜒6300余公里,形成“山随平野尽,江入大荒流”的壮阔景象,其“浪淘尽千古风流人物”的恢弘气势,成为历代文人讴歌的对象,留下不朽诗篇。
以长江为纽带,以影像为语言——9月16日,“影动长江”全国主题摄影大展在湖北省图书馆启幕。
作为2025长江文化艺术季的主体活动之一,此次大展由中国摄影家协会与湖北省委宣传部等联合主办,近200件展出作品构建出一座璀璨的视觉博物馆,摄影人以镜头为笔,尽情捕捉长江的自然之美、人文之韵与发展之变,让每一幅作品都化作讲述长江故事、延续长江文脉的生动注脚。展览从三大维度展开叙事,全方位呈现新时代长江风貌。
大河记忆生态长江
“大河记忆生态长江”板块以“共抓大保护、不搞大开发”的战略决策为指引,书写生态优先、绿色发展的绿色答卷,见证美丽中国的生态巨变。
蔡立能的《虎跳峡》,以大气磅礴的视角,定格江水汹涌奔腾的雄姿,将长江那如万马奔腾般的原始生命力,化为强烈的视觉震撼,生动彰显出母亲河的雄浑气魄。
《长江源头之雪豹》作者雷佳民介绍:“自实施长江大保护政策以来,长江流域生态发生巨变。在流域范围内,野生动物如雪豹、麋鹿等得到有效保护,种群数量持续增长。这些生态文明建设的成果,让我鼓起勇气拿起相机记录那些难忘瞬间。”
在自然保护区内,作为国家一级保护动物的黑叶猴正于林间自在活动——或专注觅食,或静卧小憩,或悉心照料幼崽,尽情享受着春日暖阳的温柔抚触。《大山里的精灵》组照吸引了众多市民打卡合影,作者李莉莉介绍,黑叶猴被称为“叶猴”,源于其偏爱取食树叶的食性特征;而“黑”字则源于其独特的体色特征。
这些作品突破文字的抽象性,让千年长江文脉不再只是史料中的冰冷符号,而是成为鲜活可感的活态记忆。
时代伟业智慧长江
“时代伟业智慧长江”板块彰显通江达海的长江所蕴含的蓬勃朝气与创新伟力,为中国经济高质量发展注入澎湃动能,助力华夏大地发展画卷开新局、展新篇。
白鹤滩水电站由万余名建设者历经12年艰苦奋斗、无私奉献筑造而成。这座“国之重器”创造了六项世界第一、两项世界第二、两项世界第三的辉煌成就,载入世界水电建设史册,树立起中国水电建设的丰碑。《中国筑坝人——世界最大清洁能源走廊建设者肖像》作者肖佳法介绍:“为致敬这群可敬的建设者,我使用中画幅相机拍摄了168名白鹤滩建设者的肖像,最终创作完成这幅大型拼版摄影作品。”
陈锡萍的《智能制造》组照,聚焦长江沿线工厂车间,完整呈现汽车智能制造从生产、组装到成品的全流程。机械臂的精准作业、自动化生产线的精密布局,既展现出强烈的科技感,又蕴含独特的工业美感,同时凸显人机协同的生产模式,见证“长江制造”向“长江智造”的跨越转型。
陈国兴的《镜鉴粮芯》组照,聚焦长江文化中的农业科研场景,精准捕捉科研人员的专注神情,展现他们为粮食安全默默探索与守护的精神。
流域映像幸福长江
“流域映像幸福长江”板块记录长江流域人民“依江而生、沿江而兴”的生活图景,呈现“百姓富、生态美”的和谐画面,绘就山水人城相融共生的新画卷。
曾朗的《长江之恋引人注目》,采用俯拍视角,宏观呈现出活动场景全貌,人群规模与活动布局清晰可见,直观地让观者感受到现场的热闹盛大,视觉冲击力十足。
2025年5月24日,武汉女足勇夺亚足联首届亚洲女足俱乐部杯联赛冠军,创造了中国女足俱乐部赛事的历史性突破。李葳《武汉女足勇夺亚冠联赛冠军》展现了女足姑娘们站在领奖台上,绽放着属于中国足球的荣耀光芒。
以空中视角聚焦城市建筑之巅——那些形态各异、匠心独运的屋顶。它们既是遮风蔽雨的实用构件,又是凝固的诗篇、跃动的音符,共同交织出建筑艺术的几何韵律。
《顶好》一语双关,既呈现了屋顶的视觉之美,又以“铸建精彩·镜览辉煌”为注脚,对湖北全省住房城乡建设显著成就给予最直观的礼赞。作者应文介绍,屋顶是城市肌理中最具特色的标识,是城市发展中创新与匠心的结晶,生动诠释着我们在人居环境提升、建筑艺术探索和高质量发展道路上的坚实步伐与璀璨成果。
陈嘉丽的《健身步道》组照,拍摄技巧精湛。采用航拍俯拍构图,将健身步道场景完整呈现,富有几何美感;创意融合地面彩绘与真实人物活动,打破现实与艺术边界,充满诙谐活力;对色彩和细节把控出色,增添生活气息。
湖北省文联主席团委员、省摄影家协会主席杨发维说,长江是地球的史记,每一滴水都承载着岁月的痕迹。拍长江,不仅要拍风景,更要拍人文;长江的魅力,也不仅在于长度绵延,更在于历史的沉淀与文化的厚重。此次大展,摄影人以不同的视角,审视这条积淀千年的长江,用镜头探秘江源的纯净、巴蜀的豪迈、荆楚的浪漫与江南的婉约,以影像书写李白笔下“朝辞白帝彩云间”的轻灵,杜甫“不尽长江滚滚来”的沉郁,以及苏轼“大江东去”的旷达。此次大展,除风光无限的湖光山色、跨江凌空的桥梁外,更多展现的是长江大保护总体战略下这条“黄金水道”焕发的生机,是来自长三角、长江中游、成渝城市群的经济长廊生动画卷。
镜头定格瞬间,文明永续流传。这些富有筋骨、温度与力量的影像,不仅为长江文化艺术季增添了绚丽色彩,更让人们得以读懂长江的过去,看见长江的现在,期待长江的未来——这,正是这场影像大展最为珍贵的文化价值所在。
该展览国庆中秋期间持续面向公众开放参观。
Copyright © 2001-2026 湖北荆楚网络科技股份有限公司 All Rights Reserved
互联网新闻信息许可证 4212025003 -
增值电信业务经营许可证 鄂B2-20231273 -
广播电视节目制作经营许可证(鄂)字第00011号
信息网络传播视听节目许可证 1706144 -
互联网出版许可证 (鄂)字3号 -
营业执照
鄂ICP备 13000573号-1
鄂公网安备 42010602000206号
版权为 荆楚网 www.cnhubei.com 所有 未经同意不得复制或镜像